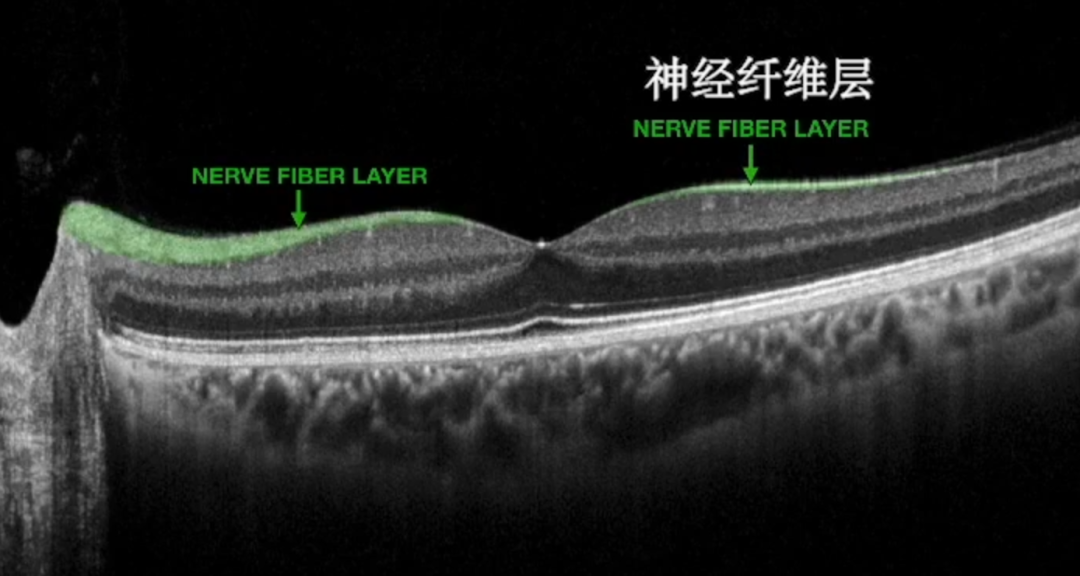
1-260113095132623.png

OCT的英文全稱為Optical Coherence Tomography,即光學相干斷層掃描技術,在生物組織活體檢測和成像方面具有應用前景,已嘗試在眼科、牙科和皮膚科的臨床診斷中應用。

以眼科為例。去醫院體檢,眼科醫生常常讓你把下巴往一臺機器上一放,幾秒鐘,一張“眼底切片”就出來了。為什么OCT這么神?一句話:它用“光”代替“聲音”,給組織做切面,分辨率達到微米,卻不用動刀、不用接觸、沒有輻射。
一,OCT成像的原理
別小看這張黑白圖,它能把視網膜每一層都放大到微米級別,連頭發絲百分之一的厚度都逃不過。OCT的原理并不神秘,核心就是“干涉”。

OCT使用的光源通常是低相干光源,這種光源發出的光具有特定的相干長度。把同一束光一分為二:一路射進樣品,被不同深度的結構反射回來;另一路去參考鏡,原路返回。兩束光重新相遇時,只要它們走過的路程差落在光源的“相干長度”之內,就會產生干涉條紋;差一丁點,信號直接歸零。
當我們用OCT掃描眼球時,不同深度的視網膜組織反射光滿足干涉條件,就能形成清晰的視網膜圖像,從而讓我們獲取眼球內部的詳細結構信息。如下圖:
二,OCT超高分辨率成像的核心
OCT超高分辨率成像的核心,其實就是光源。SuperK FIANIUM超級連續譜激光器一次補齊短板。
1,靈活可調
Pulse Picker功能讓用戶在SuperK FIANIUM全功率運行時,也能“一鍵”切換重復頻率。標準范圍0.15–78 MHz,做FLIM這類壽命測量時,想選多慢就多慢。電觸發輸出還能延時0–9.2 ns,步進15 ps,再也不用外接延時盒就能精準對時。

2,開發友好
免費的軟件開發工具包使您能夠通過第三方軟硬件來控制SuperK FIANIUM激光器。該SDK包含了完整的通信協議說明、LabView驅動程序以及C++/C#源代碼。
3,寬波長輸出
提供400 - 2400 nm輸出,覆蓋范圍廣泛,可滿足不同OCT應用對波長的多樣化需求。

4,堅固耐用
采用固態全光纖結構,能夠7×24小時穩定運行,壽命長達數千小時,無需維護。
SuperK超連續譜光源可用于譜域OCT(SD-OCT)、光譜儀型OCT(Sp-OCT)、時域OCT(TD-OCT)。

譜域OCT(SD-OCT)的參考鏡不動,光譜儀一次性收錄干涉譜,傅里葉變換后直接給出全深度信息。光譜儀型OCT(Sp-OCT)使用寬帶光源(例如SuperK超連續譜光源)來產生干涉光譜,并使用高速光譜儀檢測,通常具有數千像素和亞納米光學分辨率。時域OCT是第一代光學相干層析技術。它利用低相干光源,通過移動參考鏡對樣品特定深度進行掃描,將不同層的反射光信號轉換為干涉信號,最終重建出樣品的層析結構圖像。
對于SS-OCT,SuperK超連續譜光源可與快速掃描帶通濾波器一起使用,以有效掃描中心波長。而大多數SuperK超連續譜光源已經應用于基于光譜儀檢測(Sp-OCT)的SD-OCT。
維也納醫科大學做的對比實驗:同一雙眼睛,左邊用傳統Ti:Sapphire激光,右邊用SuperK 。哪邊更清楚,一眼就能看出來。如下圖:

樣本由維也納醫科大學 Wolfgang Drexler 教授組 Angelika Unterhuber 采集:左側 Ti:Sapphire,右側 SuperK EXTREME OCT(已升級為 FIANIUM OCT)。
頂點光電子商城還提供干涉儀的激光光源,詳情可咨詢客服。
 鄂公網安備 42011502001385號 鄂ICP備2021012849號
鄂公網安備 42011502001385號 鄂ICP備2021012849號